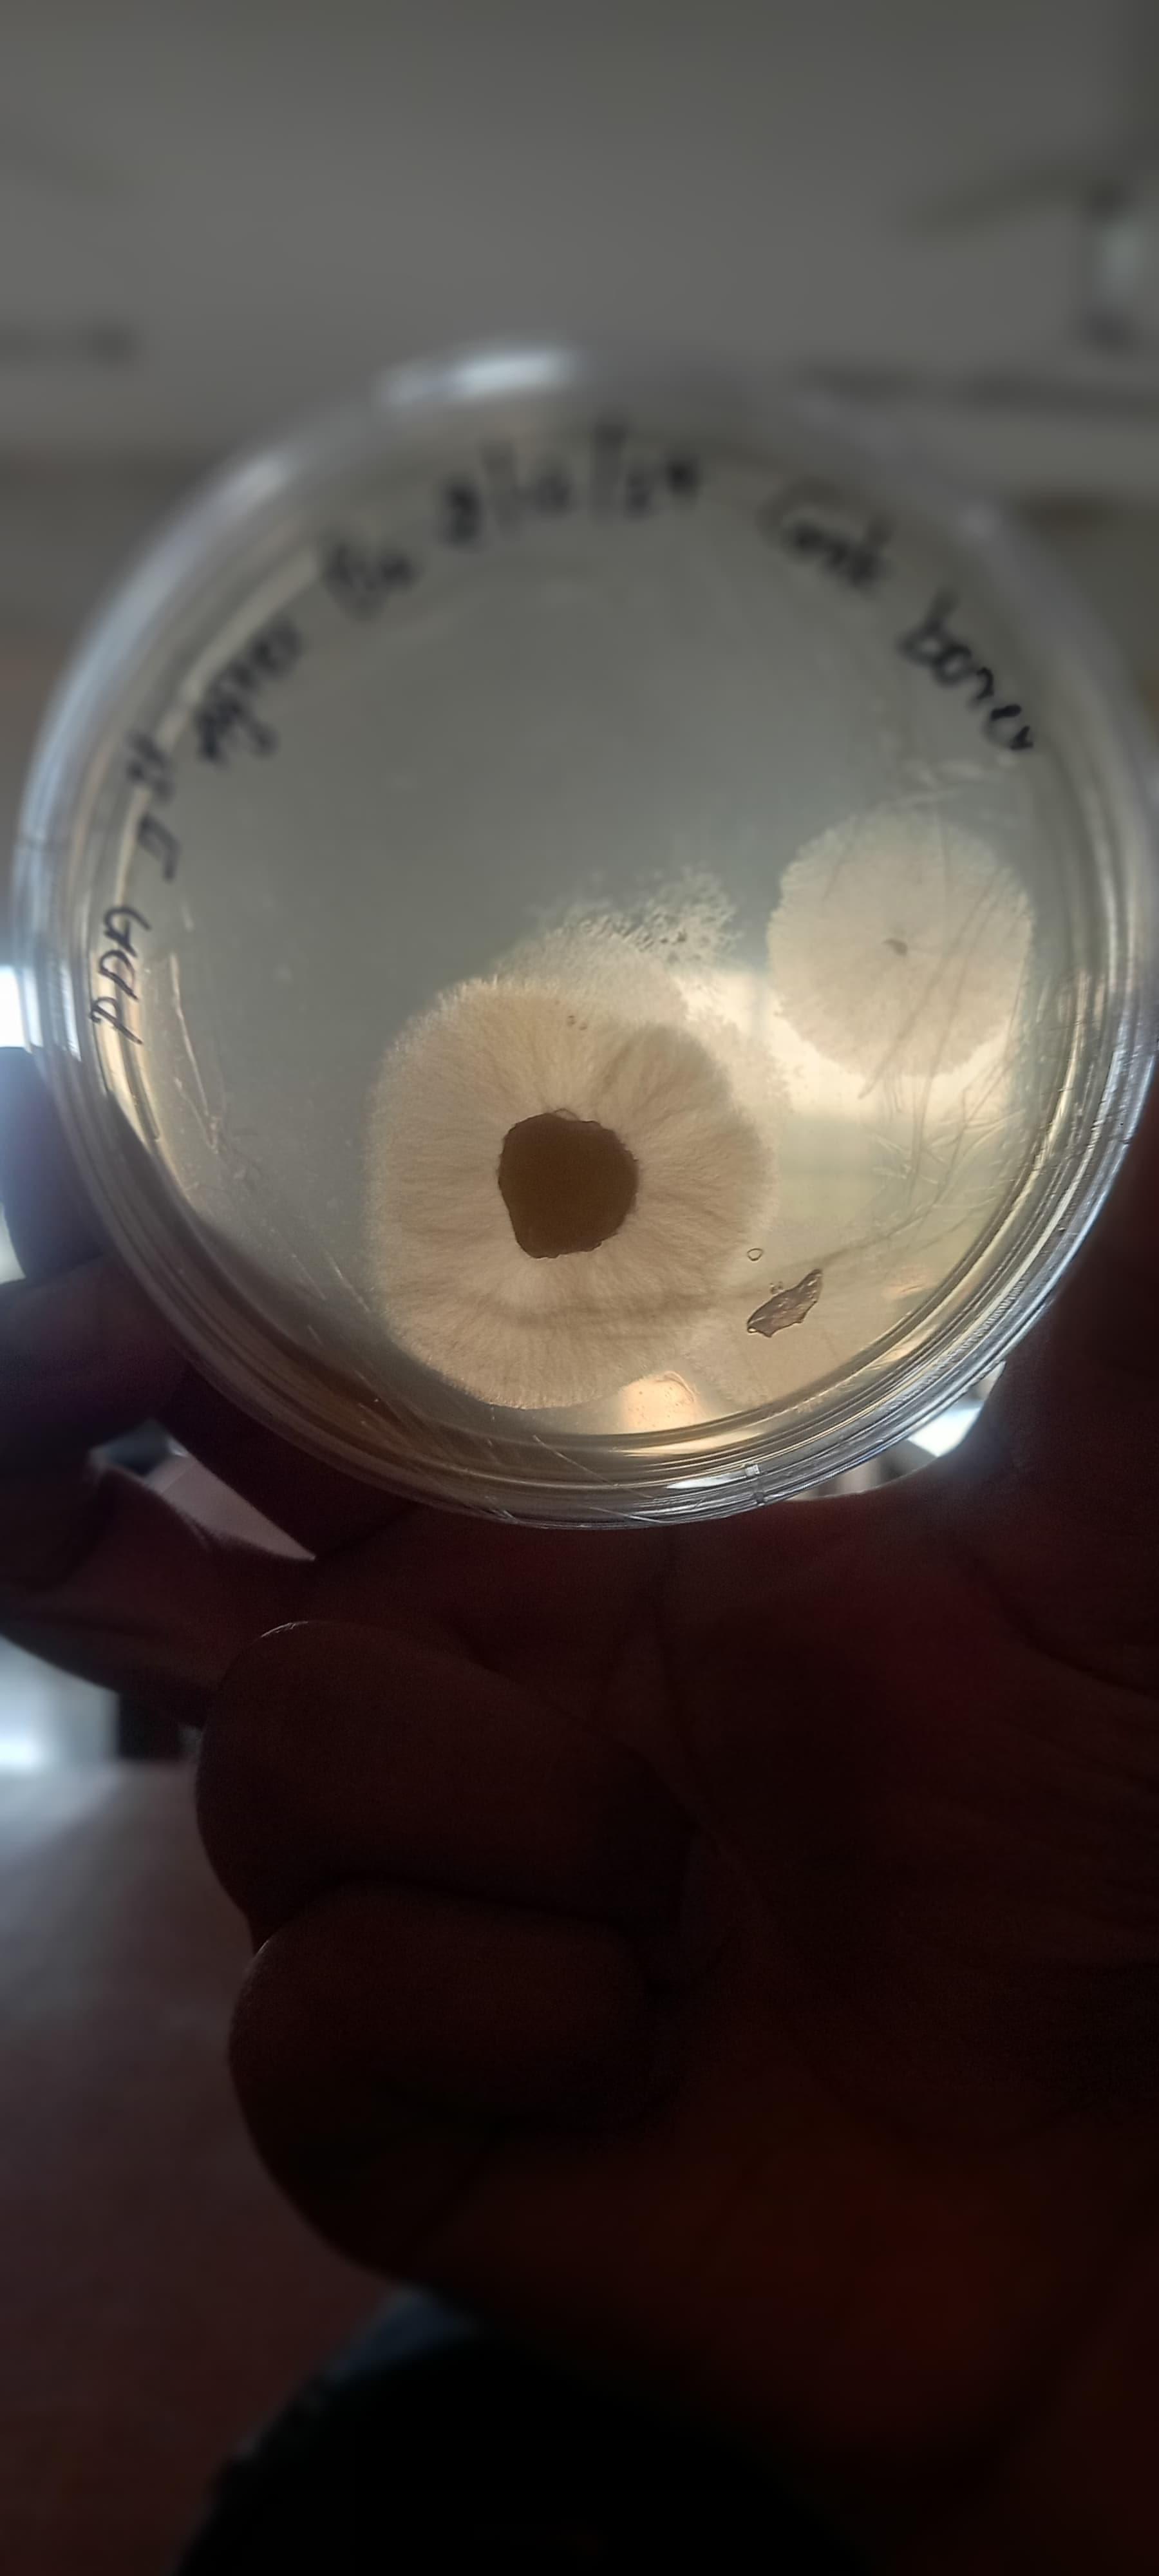

The placement opportunities for students are varied, with both private and government job prospects available. Companies like AMUL, NINJACART, and several agricultural firms visit for recruitment, although challenges persist due to the pandemic. Annual salary packages range from 1.5 to 4 lakh, with top packages reaching 7 to 9 lakh. Approximately 70% of students get placed based on interview performance, particularly in their final semesters. The college conducts a mandatory Rural Agril Work Experience Program and offers internships through ICAR and other companies like Bighaat and Akshay Kalpa.
Despite some challenges in on-campus placements, there are significant opportunities in the agricultural sector, banking, and for further studies both nationally and internationally. The college provides a placement cell to aid in job placement, and students are encouraged to prepare for competitive exams such as IAS, IBPS, and others. Many students pursue higher education or competitive exams, and the college supports research opportunities and skill development for entrepreneurship.

![University of Agricultural Sciences - [UAS]](https://image-static.collegedunia.com/public/college_data/images/logos/1438171323university of agriculture.jpg?h=71.7&w=71.7&mode=stretch)

.jpeg?h=78&w=78&mode=stretch)

.jpeg?h=78&w=78&mode=stretch)
![University of Agricultural and Horticultural Sciences - [UAHS]](https://image-static.collegedunia.com/public/college_data/images/appImage/54858_UAHS_NEW.jpg?h=111.44&w=263&mode=stretch)

![Indian Institute of Horticultural Research - [IIHR]](https://image-static.collegedunia.com/public/college_data/images/appImage/6639_IIHR_New.jpg?h=111.44&w=263&mode=stretch)



![University of Horticultural Sciences - [UHS]](https://image-static.collegedunia.com/public/college_data/images/appImage/25631_1_1.jpg?h=111.44&w=263&mode=stretch)

![University of Agricultural Sciences - [UAS]](https://image-static.collegedunia.com/public/college_data/images/appImage/25630_UAS.jpg?h=111.44&w=263&mode=stretch)

![University of Agricultural Sciences - [UAS]](https://image-static.collegedunia.com/public/college_data/images/appImage/25629_UAS_NEW.jpg?h=111.44&w=263&mode=stretch)







.jpeg?h=72&w=72&mode=stretch)

.jpeg?h=72&w=72&mode=stretch)
.png?h=72&w=72&mode=stretch)

![Karnataka State Rural Development and Panchayat Raj University - [KSRDPRU]](https://image-static.collegedunia.com/public/college_data/images/logos/1583479171karnataka.png?h=72&w=72&mode=stretch)
![University of Agricultural Sciences - [UAS]](https://image-static.collegedunia.com/public/college_data/images/logos/1441801774kk.png?h=72&w=72&mode=stretch)

![Acharya NG Ranga Agricultural University - [ANGRAU]](https://image-static.collegedunia.com/public/college_data/images/logos/1503923184logo.png?h=72&w=72&mode=stretch)

![University of Horticultural Sciences - [UHS]](https://image-static.collegedunia.com/public/college_data/images/logos/14634762819885919_orig.jpg?h=72&w=72&mode=stretch)
![Tamil Nadu Agricultural University - [TNAU]](https://image-static.collegedunia.com/public/college_data/images/logos/uv25901.jpg?h=72&w=72&mode=stretch)
![Sri Siddartha First Grade College - [SSFGC]](https://image-static.collegedunia.com/public/college_data/images/logos/1428820048Capture.jpg?h=72&w=72&mode=stretch)
![Central Agricultural University - [CAU]](https://image-static.collegedunia.com/public/college_data/images/logos/1433933037jp.jpg?h=72&w=72&mode=stretch)
![Indian Institute of Horticultural Research - [IIHR]](https://image-static.collegedunia.com/public/college_data/images/logos/1561357689logo7.png?h=72&w=72&mode=stretch)
![Rai Technology University - [RTU]](https://image-static.collegedunia.com/public/college_data/images/logos/14225091472b13883.jpg?h=72&w=72&mode=stretch)

![University of Agricultural Sciences - [UAS]](https://image-static.collegedunia.com/public/college_data/images/logos/1460805769UniversityofAgriculturalSciencesDharwad.jpg?h=72&w=72&mode=stretch)
![University of Agricultural and Horticultural Sciences - [UAHS]](https://image-static.collegedunia.com/public/college_data/images/logos/1422531917logo.png?h=72&w=72&mode=stretch)


Comments